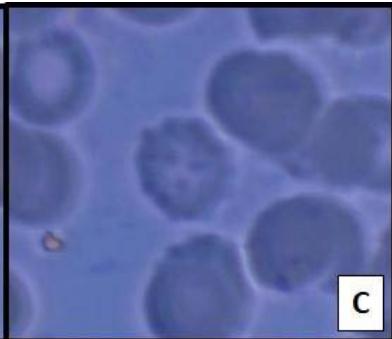
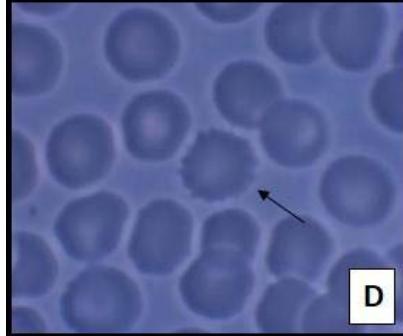
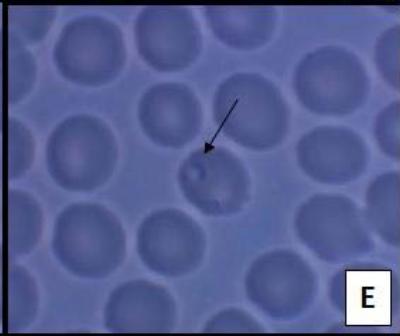
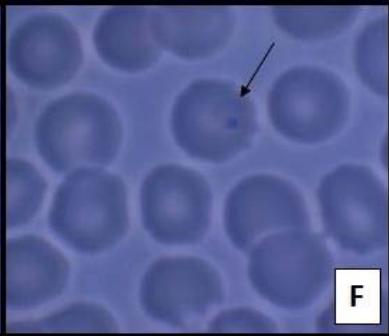

Malaria is caused by the protozoan Plasmodium and its infection can occur in several ways, being the most common through the bite of the female mosquito Anophelesdarling. The life cycle o f the vector is related to the dynamics of the ecosystem that lives, situations such as global warming generate a great concern regarding the possible amplification of the reproduction capacity of vectors according to climate change. These diseases are much more frequent in regions where the climate is tropical, such as Brazil. The incidence of the vector is characterized by several factors, such as biological, ecological, sociopolitical, cultural, and economic factors, the latter influence health expenditures in Brazil regarding the preventive measures of infection. The economic impact includes expenses with any health care, lost service days, loss of classes in the education system, as well as lower-income at work due to brain injuries, among others. Malaria breeds poverty and poverty breeds Malaria.
## I. INTRODUCTION
The oldest known diseases in the world are those transmitted through vector mosquitoes. Reports of the papyri of Óber (3550 BC) mention that during the floods of the Nile River many people were affected by an intermittent fever, body pain, and yellowing of mucous membranes, many cities were decimated by the disease (SHEIBAN, 2006). There were beliefs that the disease was derived from the stench of the swamps, contaminated air and for a long time there was no scientific progress about the etiology of the disease (FAUSTINO, 2016).
Currently, it is known that the protozoan Plasmodium (Apicomplexa) causes Malaria disease and its infection can occur in several ways, being the most common through female mosquito bite by Anopheles darlingi (GITTA, 2020). After the bite, assuming that the mosquito is contaminated with the protozoan, it is inoculated in the forms of sporozoites, which migrate to the human liver where they reproduce asexually (ORFANO, 2016).
The vector life cycle is directly related to the ecosystem dynamics in which they live, situations such as global warming, generate a great concern regarding the possible amplification of the reproduction capacity of vectors according to climate change. However, the climate relationship and the incidence of malaria transmission are still little studied, besides having a very complex relationship that varies according to the studied site. This kind of disease is much more frequent in regions where the climate is tropical, such as Brazil (FERREIRA 2015).
According to data collected by the Foundation of Health Surveillance, many regions situated in North Brazil, such as Amazonas State can be classified as "high risk" according to the malaria case record data.
The lack of information in hard-to-reach regions on malaria prevention and treatment methods makes it difficult to control the disease, leading people to believe that Malaria can be transmitted through the ingestion of water and food. Citing analogous cases, in villages, it is believed that herbal tea can minimize the symptoms of the disease and even cure the infected (WOLFHART-COUTO, 2020). Issues involving climate change and its impact on human health should be analyzed and discussed to propagate current information and future perspectives on new alternatives for prevention, diagnosis, and more effective treatments (OMS, 2015).
a) Species and morphology of the parasite Plasmodium spp.
Malaria's laboratory diagnostic manual (2009) says that parasites of the genus Plasmodium, vary in size, shape, and appearance, confusing with foreign elements such as fungi, bacteria, and other protozoa and thus hindering the diagnosis of Malaria. Microscopically the shapes of the species resemble rings, schizonts, and gametocytes are rounded.
For the distinction among Plasmodium species, blood smears are the best method because allow analyzing the shape and diameter of infected human red blood cells (Fig. 1) (FERREIRA, 2012).
Plasmodium falciparum has an erythrocytic form with trophozoites and small formation, hyaline and annulate inside the parasitized red blood cells and ameboid movement not as intense as in Plasmodium vivax. After Giemsa staining, the parasite reveals blue staining in the cytoplasm and cracks in the stroma of the red blood cells, called Maurer granulations, and is observed in the initial phase of the parasite in the red blood cell. Gametocytes are elongated and curved with slightly tapered extremities (Fig 1) (REY, 2008).

Source: Prepared by the author (2020). Figure 1: A and B: Plasmodium vivax Schizont forms; Multiparasitic red blood cells by trophozoites of Plasmodium falciparum; D: Red blood cells infected by Plasmodium sp. associated with the formation of knobs (arrow); E and F: Trophozoite of P. falciparum into red blood cells with ring form (arrow).
Plasmodium vivax has an erythrocytic and young trophozoites as a rounded disc of intense activity inside the red blood cell, the refringent nucleus appears as a bright granule. In the corded preparations (Giemsa) the young trophozoite appears in the form of a small blue mass of cytoplasm, ovoid or rounded with dense chromatin and strongly colored red. As the cell membranes of erythrocytes change, they emit a thin red granulation flame of Schüffner. In pre-schizonts, the cytoplasm is more abundant, and the pigment granules are larger and darker. Gametocytes appear later than the trophozoites. Female gametocytes present almost the entire volume of dilated red blood cells (10-11 $\mu$ m in diameter). They are usually 3 to 8 times more frequently than males. Microgametocytes are slightly smaller and have pale blue cytoplasm (REY, 2008).
Plasmodium malariae has less active trophozoites than $P.$ vivax and performs the sluggish movement. In the cytoplasm, pigment grains are few numerous, however, it has the largest volume than the other Plasmodium. Young trophozoites are the first to appear in the bloodstream, exhibit in ring form, occupying one-third of the diameter of red blood cells. In $P$ malariae infections there are no Schüffner granulations and there are rare occasions that changes occur called Ziemann granulations that are larger and coarser than Schüffner. The merocyte forms from 6 to 12 merozoites arranged as the petal of a flower in the residual cytoplasm, where the entire pigment is stored. Gametocytes have almost the same morphology as $P$ vivax, differing only that their size is smaller (REY, 2008).
# b) The
malaria cycle begins when the female Anopheles sp. injects, through saliva, Plasmodium sporozoites, into the human bloodstream. The pre erythrocytic phase occurs in the liver, where sporozoites migrate and develop into schizonts. These schizonts rupture by releasing merozoites and infecting erythrocytes and then the parasite multiplies asexually (the so-called erythrocyte cycle). Merozoites develop
into ring-stage trophozoites and some of these mature for schizont that breaks up releasing merozoites. Next, some trophozoites differ in gametocytes (ASHLEY, PHYO, WOODROW 2018).
 Figure 2: Plasmodium life cycle.
Source: Prepared by the author (2020), adapted on Merck & Co (2020).
During blood intake, the mosquito ingests male (microgametocytes) and female (macrogametocytes) gametocytes, starting the sporogonic cycle. In the mosquito stomach, microgametes penetrate macrogametes, producing zygotes. These zygotes become mobile and elongated, evolving to oocinetes that invade the wall of the mosquito's middle intestine, where they develop into oocysts, they grow, rupture and release sporozoites, which move to the salivary glands of the mosquito. Inoculation of sporozoites in a new human host perpetuates the life cycle of the parasite (Fig. 2) (LOURENÇO, 2018).
### c) Vector/species transmitter Malaria
The mosquito Anopheles darlingi is one of the malaria vectors and the main species of transmission to Brazilian territory, which spreads through the bite of a female infected by the protozoan Plasmodium, which causes the disease. This species has wide geographical distribution in the Americas, extending from southern Mexico to northern Argentina, due to high humidity, the average temperature is between $20 - 30^{\circ}\mathrm{C}$, so it is more likely to spread in the Amazonia. Under optimal conditions, the mosquito populations can reach a sufficient number of individuals to spread the Malaria disease (BARBOSA, 2014).
Only mosquito females feed on human blood tissue mandatory for egg development. Males feed only on plant saps and it has been not considered vectors disease.
Larvae develop in stagnant water and are more prevalent in periods of heavy rainfall, the species generally remain absent in regions with long periods of drought. However, even when present in low density, the species can maintain a high rate of Malaria transmission (BUENO, 2017).
### d) Diagnosis and Treatment
The use of antimalarials intensified with the outbreak of SARS-CoV-2 and was used for the early treatment of the infection without any clinical proof of its efficacy. More recent studies prove that these drugs are not effective in treating this infection at any stage of its cycle (OMS, 2020). This fact brings concern due to the ability to acquire resistance to Chloroquine of some Plasmodium species, and this is no longer effective for reducing malaria viral load. Malaria is diagnosed from symptoms such as intermittent fevers, tremors, chills, sweating, severe headache, and especially yellowing in the mucous membranes.
For diagnosis, rapid tests are performed that are based on the capture of malaria protein derivatives (target antigens) by monoclonal antibodies reactive to such antigens found in infected peripheral blood or complementary tests such as Polymerase Chain Reaction (PCR).
Patients with positive diagnoses, symptoms, and laboratory manifestations should be isolated and referred to emergency medical care to receive appropriate treatment (BRASIL, 2010). The laboratory manifestations are severe anemia, hypoglycemia, metabolic acidosis, renal failure, microvascular dysfunction, and hyperlactatemia.
Immediately after the diagnosis, start treatment with medicines made available by the Unified Health System (SUS), so-called antimalarials such as chloroquine, quinine, primaquine, doxycycline, and mefloquine. The dosage depends on the parasite species and patient age (MORENO et al., 2017). For $P.$ vivax and Plasmodium ovale infection, the Ministry of Health (Brazil) recommends the use of chloroquine and primaquine while the treatment of Plasmodium falciparum infection non-severe is given with artemether + lumefantrine or artemether + mefloquine as the first choice and severe Malaria is Artemisinin derivatives. To Plasmodium malariae has only used chloroquine.
Drug treatment in severe cases has the purpose of interrupting schizogonia, which is responsible for the symptomatology in patient; such as destruction of the parasite in the tissue cycle (hypnozoites) of $P$. vivax, avoiding late relapses; interruption of transmission with the use of drugs that prevent the sexual development of the parasite (DE SOUZA et al., 2019).
According to the World Health Organization (2019), there is still no vaccine that generates a persistent immune response to Malaria and the substances currently available are drugs that losing their power leading to resistance of Plasmodium spp.
## II. MATERIALS AND METHODS
The present work used the method based on the Experimental article Planning Factorial: A brief Review (OLIVEIRA et al., 2018), published in the journal International Journal of Advanced Engineering Research and Science (IJAERS).
To identify articles that talk about climate change in the incidence of Malaria from the uncontrolled reproduction of the propagation vector A. darlingi, searches were performed in the databases PubMed, ScienceDirect, Scielo, Google Scholar, Dialnet, WorldwideScience.org, Tandfonline, Dialnet, Microsoft Academic, DataSus and the Ministry of Agriculture (MAPA).
In the present study, the research strategy on the subject consisted of the use of keywords in English: 1. Climate Change in Brazil;
2. The life cycle of the Anopheles darlingi vector;
3. Impact of climate change on the A. darlingi life cycle;
4. Sensitive socioeconomic
factors. The following filters have been added to the search in ScienceDirect: only journals; title, abstract; Keywords.
After consulting all the databases and using the search strategy adopted, repeated articles were identified between the different data sources. The criteria and filters for the inclusion of the articles in this work were: Original research articles that conceptualize the relationship between the effects of climate change on the incidence of Malaria through the vector A. darlingi, in different types of research fields, covering research completed in the present languages: Portuguese, English, and Spanish.
The papers taken from the study were grouped in the following order: repeated, irrelevant, other publication formats (edict, short communications, perspectives, letters), and other languages that were not well understood. Besides, manual searches were evaluated in bibliographic references of the review articles found with previously determined keywords.
## III. DATABASE STRUCTURE
Further studies are needed to identify the endemic direction and malaria morbidity in the population. Therefore, because of the different searches in the databases, 55 articles were found that cover the theme addressed in this study. After the removal of the duplicate articles, the exclusion criteria were applied. Of the total of 50 articles studied, 19 of them were removed according to the criteria adopted. Two duplicate articles were excluded and three original research articles were retrieved. Through manual search were retrieved two more articles (Fig. 3).

Source: Prepared by the author (2020). Figure 3: Flowchart of identification and selection of articles prepared by the authors, 2020.
Finally, through a word cloud was visually identified the keywords used to collect information in databases. Larger words indicate a higher incidence of Malaria according to the region where it is located and the lowest, addresses the lower incidence (Fig. 4).
 Figure 4: Keyword cloud produced by authors to elaborate on the work, 2020.
Source: Prepared by the author (2020).
## IV. RESULTS
Malaria infection rate not only depends on vector and parasite but also regional weather conditions, preventive care, and post-infection treatment. The incidence of the vector is characterized by several factors, such as biological, ecological, sociopolitical, cultural, and economic factors, the latter influencing health expenditures in Brazil concerning preventive measures of infection (SIQUEIRA et al., 2018).
### a) Economic losses caused by Malaria in Brazil
The social and economic losses caused by Malaria affect pauperized populations, far from access to health services and living in precarious conditions of housing and basic sanitation. According to Brazil Communication Company - BCC (2019), the nine states that make up the Amazon have the Municipal Human Development Index (M-HDI) below 0.750 and that of Brazil 0.761. This index seeks to measure the health, education, and income of the population and express the "human development" of the region. At the economic level, Malaria is strongly linked to poverty, where cases occur predominantly in $80\%$ of rural areas and $11\%$ in mining and settlements, which are priority areas for Malaria because they are highly receptive (BRASIL, 2019).
The economic impact includes expenses with any health care, lost service days, loss of classes in the education system, as well as lower-income at work due to brain injuries, among others. Malaria Generates Poverty and Poverty Breeds Malaria (CARDONA-ARIAS, 2019).
In 2013, global spending on malaria intervention was around 2.6 billion. In 2015, the Pan American Health Organization had estimated health expenditures in the range of US $5.1 billion. In Brazil, the total number of hospitalizations for Malaria from 1998 to 2005 generated a cost of R$ 19 billion and an average cost of R$ 161.52 per hospitalization. Hospitalizations for unspecified malaria cost R$ 7.6 billion to the Brazilian Unified Health System (ROSSETO et al., 2013).
Currently, the economic burden of malaria epidemics remains unclear. Studies conducted in stable transmission areas have established that Malaria causes considerable losses for families in the form of income, treatment costs, loss of schooling, and decreased agricultural production (MOURão, 2018).
### b) Fifth IPCC Report
The Intergovernmental Panel on Climate Change (IPCC) is the leading international body for the assessment of climate change. In 1988, through the United Nations Environment Program (UNEP) and the World Meteorological Organization (WMO), an agreement was established to which, these entities would provide the world with a clear scientific view of the current state of knowledge about climate change and its potential environmental and socioeconomic impacts.
According to the fifth report released, the IPCC states that global warming is not a hoax, the atmosphere and oceans have warmed, glaciers have decreased and greenhouse gas concentrations are increasing considerably. The report highlights the ratio of greenhouse gases to the warming of the atmosphere and oceans, wherein 2011 the concentrations of the best-known gases, carbon dioxide (CO2) and methane (CH4), were 391 parts per million and 324 parts per billion, respectively.
The report also highlights the likely human influence on the warming of the atmosphere, especially about the emission of Greenhouse Gases (GHG) in the atmosphere, which reached the highest concentration in the last 800,000 years, as this is the main cause of the warming of the atmosphere, so to limit climate change, the report recommends drastically reducing greenhouse gas emissions (IPCC, 2008)
The forecast for the increase in temperature in the 21st century was made from four different scenarios, according to the concentrations of gases of the effect studies in the atmosphere. In the most optimistic scenario, the earth's surface temperature can increase by up to $0.7^{\circ}\mathrm{C}$ by the year 2100, in the most pessimistic scenario the temperature increase increases from $4^{\circ}\mathrm{C}$ for this same period (FERREIRA, 2017).
### c) Climate change forecast for Brazil
According to the first National Assessment Report (NAR) published in 2015, the Brazilian panel on climate change was predicted for the Amazon biome, a $45\%$ decrease in rainfall distribution for the region and an increase in temperature of up to $6^{\circ}\mathrm{C}$ by the year 2100 (PBMC, 2014).
For the Caatinga biome, present in the Northeast region of Brazil, a decrease in rainfall distribution of up to $50\%$ is also predicted, and an increase of up to $4.5^{\circ}\mathrm{C}$ by the end of the century. For the Cerrado biome, an increase in temperature is expected by the end of the century of up to $5.5^{\circ}\mathrm{C}$ and a decrease in precipitation of up to $45\%$. In the Pantanal biome, relativity is that the temperature will rise to $4.5^{\circ}\mathrm{C}$, while the distribution of rainwater is reduced by up to $45\%$. These two biomes are most common in the Midwest and Southeast regions of the country. In the South region, a forecast was also made for the Pampa biome, where an increase of up to $3^{\circ}\mathrm{C}$ in temperature was projected by 2100, and different from the forecasts for out as regions predicted intensification of up to $40\%$ in the distribution of rainfall in the region (FAUSTINO, 2016).
The projection for the amount of rainfall in the country will decrease in most regions. A fact associated with tropical ocean patterns, which according to projections will be abnormally warmer in the Pacific and
Atlantic, these patterns modify the wind regime, inhibiting the transport of moisture over tropical Brazil, inhibiting the formation of clouds (TAUIL, 1985).
### d) Impact of environmental changes on malaria transmissibility
The Amazon region suffers annually from deforestation and burning for the expansion of agriculture, leading to environmental changes conducive to the emergence of new breeding sites for vectors transmitting Malaria (GIMING et al., 2002; VITOR et al., 2009; MUNGA et al., 2006; GIL et al., 2007).
Besides, the average variation in precipitation, temperature, and humidity in the previous two months also suggest increased malaria incidence rates (OESTERHOLT et al., 2006; GOMEZ-ELIPE et al., 2007; VASCONCELOS et al., 2006). The union of climate and environmental changes can alter the vector capacity due to increased survival of A. darlingi mosquitoes and consequently the population of these (MARTIN, 1995). Environmental changes together can trigger the emergence of new endemic areas and malaria transmission throughout Brazil (DA SILVA-NUNES, 2010).
### e) Malaria Incidence
According to the Brazilian Ministry of Health, the North region has the highest number of reported cases in the rest of the country. This notification in a regionalized manner occurs due to several factors influenced by the forest such: environmental conditions such as high temperature and humidity decrease the cyclic period of the virus, multiplying rapidly and increasing the transmissive capacity of the mosquito. Also, such conditions affect the reproductive factor of A. darlingi and thus the number of vectors grows alongside the viral load of Plasmodium, Demography, the North region is scantly populated and many people live scattered or in difficult-to-reach situations; resistance to treatment, in some localities there are strains of Plasmodium, resistant to Hydroxychloroquine, Chloroquine, Primaquina and other drugs already approved for reduction of viral load and mass treatment. Considering data collected by the Brazilian health information system (DataSus), the Amazon region has more than 80,000 reports of malaria cases for the period from January to March 2018 and 2019 alone (BRASIL – DataSus). The states of Amapá, Pará, and Roraima are endemic to Malaria in Brazil. The Tocantins has the lowest incidence.
In the extra-Amazonian region, notifications are extremely lower, with only 35 cases, also for the same period.
Table 5: Reports of malaria cases in Brazilian states.
<table><tr><td>UF</td><td>2018
(January to March)</td><td>2019
(January to March)</td></tr><tr><td>AC</td><td>9.787</td><td>3.334</td></tr><tr><td>AM</td><td>19.280</td><td>11.240</td></tr><tr><td>AP</td><td>2.726</td><td>2.879</td></tr><tr><td>MA</td><td>308</td><td>132</td></tr><tr><td>MT</td><td>186</td><td>81</td></tr><tr><td>PA</td><td>10.751</td><td>7.550</td></tr><tr><td>RO</td><td>1.684</td><td>1.970</td></tr><tr><td>RR</td><td>6.143</td><td>4.666</td></tr><tr><td>TO</td><td>12</td><td>3</td></tr><tr><td>Amazonian region</td><td>50.877</td><td>31.855</td></tr><tr><td>AL</td><td>2</td><td>0</td></tr><tr><td>BA</td><td>56</td><td>1</td></tr><tr><td>CE</td><td>10</td><td>0</td></tr><tr><td>DF</td><td>9</td><td>3</td></tr><tr><td>ES</td><td>9</td><td>1</td></tr><tr><td>GO</td><td>17</td><td>3</td></tr><tr><td>MG</td><td>9</td><td>0</td></tr><tr><td>MS</td><td>1</td><td>0</td></tr><tr><td>PB</td><td>3</td><td>0</td></tr><tr><td>PE</td><td>4</td><td>0</td></tr><tr><td>PI</td><td>4</td><td>0</td></tr><tr><td>PR</td><td>9</td><td>1</td></tr><tr><td>RJ</td><td>20</td><td>3</td></tr><tr><td>RN</td><td>4</td><td>0</td></tr><tr><td>RS</td><td>4</td><td>0</td></tr><tr><td>SE</td><td>7</td><td>1</td></tr><tr><td>SP</td><td>0</td><td>0</td></tr><tr><td>Extra-Amazon</td><td>31</td><td>4</td></tr></table>
The Oswaldo Cruz Foundation (Fiocruz) is an institution that collects data and disseminates information about Brazilian health and social development and to the malaria problem, considers the Amazon region the most vulnerable in Brazil in terms of transmissibility of the disease and also for favorable environmental factors (Fiocruz, 2020). Socioeconomic factors in the region may also be directly related to the large difference of cases between the Amazon region and the extra-Amazon region since they are predictors of good or poor health conditions. Therefore, environmental conditions and socioeconomic factors can be a sign of the increase or fall of notifications, hospitalizations, and deaths.
The difficulties faced in the Amazon region, such as: reaching places of difficult access and demographic dispersion hinder actions of prevention, diagnosis, and treatment of the disease, thus the lethality of the disease becomes increasingly increasing and the epidemic is installed. From January to June 2017 and 2018, the rate of hospitalizations showed a slight drop of $1\%$ and deaths increased by $450\%$. (Table 6 and 7).
Table 6: Number of hospitalizations due to malaria cases in the Amazon and Extra-Amazon regions.
<table><tr><td>Amazon region</td><td>2017
(January to June)</td><td>2018
(January to June)</td><td>Difference%</td></tr><tr><td>Internações</td><td>735</td><td>726</td><td>-1%</td></tr><tr><td>Extra-Amazon</td><td>2017
(January to June)</td><td>2018
(January to June)</td><td>Difference%</td></tr><tr><td>Hospitalizations</td><td>84</td><td>109</td><td>+ 30%</td></tr></table>
Table 7: The number of deaths due to malaria cases in the Amazon and Extra-Amazon regions.
<table><tr><td>Amazon region</td><td>2017
(January to February)</td><td>2018
(January to February)</td><td>Difference%</td></tr><tr><td>Deaths</td><td>2</td><td>11</td><td>+450%</td></tr><tr><td>Extra-Amazon</td><td>2017
(January to February)</td><td>2018
(January to February)</td><td>Difference%</td></tr><tr><td>Deaths</td><td>1</td><td>2</td><td>+100%</td></tr></table>
According to tables 6 and 7, reports of malaria cases increased in extra-American regions by about $30\%$ and deaths by $100\%$. These localities previously did not present ideal conditions for disease proliferation. However, global warming and the few malaria preventions and treatment policies favor the reproductive factor of A. darlingi and the spread of Plasmodium among people. In this way, new endemic areas arise.
If no measures are taken to reduce global warming, the world's tropical regions both endemic (Amazonian) and non-endemic (Extra-American) regions will suffer progressively with the increase in cases and deaths each year. Giving up efforts to contain Malaria can promote even greater economic losses than investing in prevention, control, and treatment measures (CARDONA-ARIAS, 2019).
For residents of regions with high endemic peak, it is recommended to adopt protective measures such as: not exposing yourself during sunrise and sunset, a period of high presence of the female A. darlingi, sleeping indoors and previously detested with insecticides based on pyrethrin, a substance that causes paralysis and death in insects. In general, it is not recommended to visit such regions, but if it is extremely necessary, important preventive measures can be adopted, such as chemoprophylaxis consisting of using antimalarial drugs before visiting the site. The physician who prescribes antimalarial should consider the region and species of Plasmodium, which has a higher incidence, to avoid cases of viral resistance (MEIRELES, 2020).
For diagnosis, the World Health Organization (WHO) recommends the use of rapid diagnostic tests (RDT's), antigens produced by the parasite present in human blood. They are simple execution, high reliability, and the result is easy to interpret, being possible mass testing, to isolate and treat the infected. The treatment has advanced a lot over the years, mainly due to the high demand for new prophylactic drugs since Plasmodium sp., has high selection capacity and resistance to antimalarials widely used worldwide, such as Chloroquine, Hydroxychloroquine, and Primaquine. Currently, the treatment is performed with Artemisinin-based combination therapies (ACT's) that are extremely effective and eliminate much of the viral load present in the bloodstream, contributing to the reduction of hospitalizations and deaths (GENDROT, 2020).
In endemic countries, some people have already acquired immunity against the disease, so it is possible to develop a vaccine that generates an immune response and protects against the effects of
Malaria. For various diseases, induction of antibodies via vaccination is the best form of control, but for Malaria there is still no $100\%$ effective vaccine. According to the WHO, in 2015 a protein-based recombinant vaccine capable of generating immune response was licensed, the popular name "RTS S/A S01" mosquitoes, the only one approved for malaria prevention. It induces antibodies that prevent Plasmodium from infecting the liver, has an average efficacy of up to $40\%$, and if administered early increases to $86\%$ (BBC News, 2020).
## V. CONCLUSION
Prevention by chemotherapy alone is insufficient to reduce cases and deaths from malaria, as Plasmodium can easily acquire resistance to these drugs. Constant investment in research is essential to design new antimalarial molecules and avoid resistance. A good antimalarial control program should gather environmental and epidemiological data, considering the Brazilian spatial heterogeneity and how the disease is transmitted, to identify endemic sites and administer the most effective antimalarial treatment.
The word cloud intuitively and appealingly identified the endemic areas most and least affected by Malaria in Brazil with the size of their font. Thus, being able to help the health system to guide the local population on the control, prevention, and antimalarial treatment present in the region.
Generating HTML Viewer...
References
43 Cites in Article
Elizabeth Ashley,Aung Pyae Phyo,Charles Woodrow (2018). Malaria.
Ledayane Barbosa,Raimundo Souto,Ricardo Ferreira,Vera Scarpassa (2014). Composition, abundance and aspects of temporal variation in the distribution of Anopheles species in an area of Eastern Amazonia.
Bridy Ditombi,Julienne Minko,Roméo Tsamba,Jacques Ngomo,Tatiana Nymane,Fanny Ognagosso,Noé M’bondoukwe,Denise Mawili-Mboumba,Marielle Akotet (2015). Comparative performance of four malaria rapid diagnostic tests, Vikia Malaria Pf/Pan, Meriline-Meriscreen Pf/Pv/Pan, Right Sign Malaria Pf/Pan, and Right Sign Malaria Pf, among febrile patients in Gabon.
Brasil (2019). Malaria: What it is, causes, symptoms, treatment, diagnosis, and prevention.
Brasil (2020). Malaria treatment guide in Brazil.
Ministério Brasil,Da Saúde Banco de dados do Sistema Único de Saúde -DATASUS.
Rian Bueno,Pereira (2017). SISS-Geo, Fiocruz. Malaria in the Atlantic Forest biome: species and related environmental conditions.
Jaiberth Cardona-Arias,Walter Salas-Zapata,Jaime Carmona-Fonseca (2019). Determinación y determinantes sociales de la malaria: revisión sistemática, 1980-2018.
Silva-Nunes Da,Mônica (2010). Impact of environmental changes in malaria transmission and perspectives for disease control in rural settlement areas of the Brazilian Amazonia.
De,Magno Oliveira Experimental Planning Factorial: A Brief Review.
Ranieri De Souza Santos,Sales (2019). CROSS-CUTTING STUDIES ON MALARIA (Plasmodium falciparum): A SYSTEMATIC REVIEW.
Pedro Faustino,Santos Miguel Dos (2016). Malaria chemotherapy: prospects for the future.
Marcelo Ferreira,Urbano (2012). Contemporary Parasitology. 1ª Edition.
Maria Ferreira,M Eugenia,Costa (2015). Tropical diseases": climate and public health. Climate change and the occurrence of malaria in the area of influence of the Itaipu reservoir.
Samuel Nascimento,Fernanda Severo,André Guerrero,Fabiana Damásio,Nara Vieira,Bárbara Vaz,June Scafuto,Enrique Bessoni,Marlon Lima (2020). EXPERIÊNCIA DE GOVERNANÇA DIGITAL: MEDIAÇÕES TECNOLÓGICAS PARA A GESTÃO DO CONHECIMENTO EM POLÍTICAS PÚBLICAS INTERSETORIAIS..
Luiz Gil,Mauro Tada,Tony Katsuragawa,Paulo Ribolla,Luiz Silva (2007). Urban and suburban malaria in Rondônia (Brazilian Western Amazon) II: perennial transmissions with high anopheline densities are associated with human environmental changes.
John Gimnig (2002). Culicidae) larvae in artificial habitats.
Alberto Gomez-Elipe (2007). Prediction of malaria incidence based on monthly case reports and environmental factors in Karuzi, Burundi, 1997-2003.
(2008). INTERGOVERNMENTAL PANEL ON CLIMATE CHANGE (IPCC).
Aline Loureiro,Cordeiro (1926). Diversity in genes related to resistance to insecticides and biological rhythms in Anopheles darlingi ROOT.
Prasanta Bal (1995). Climate Change Projections and its Impacts on Potential Malaria Transmission Dynamics in Uttarakhand.
Ministério Da Saúde (2020). Contas Nacionais da Força de Trabalho em Saúde: Um Manual.
Ministry Of Health; Ministry Of Health (2010). A practical guide to malaria treatment in Brazil.
Fabio Mourao,Rodrigo (2014). Malaria surveillance in the Brazilian Amazon.
Stephen Munga (2006). Associação entre a cobertura do solo e a produtividade do habitat de vetores da malária nas terras altas do oeste do Quênia.
Mjam Oesterholt (2006). Spatial and temporal variation in malaria transmission in an area of low endemicity in northern Tanzania.
Alessandra Orfanó,Da Silva (2016). Different approaches to the interaction between Anopheles spp. and Plasmodium spp: establishing a laboratory murine model, studying the escape of sporozoites and the microbiota.
Hoda Atta,Caroline Barwa,Ghasem Zamani,Robert Snow (2015). Malaria and complex emergencies in the Eastern Mediterranean Region.
Pbmc (2014). Technical Summary.
Luis Rey (2008). Rey Parasitologia. 4ª edição.
Erika Rossetto,Valeska (2013). Evaluation of the Hospital Information System how a tool for the malaria surveillance in Amazônia Legal. Brazil, 1998-2005.
Eliane Pawlowski Oliveira Araújo,Jacqueline Pawlowski Oliveira,Edison Corrêa (2018). POTENCIALIZANDO O ACERVO DE RECURSOS EDUCACIONAIS EM SAÚDE: ANÁLISE DA PRODUÇÃO DO NESCON/UFMG COM VISTA A INCREMENTAR A DISPONIBILIZAÇÃO E O COMPARTILHAMENTO DE OBJETOS DE APRENDIZAGEM.
Cíntia Vasconcelos,Evlyn Novo,Maria Donalisio (2006). Uso do sensoriamento remoto para estudar a influência de alterações ambientais na distribuição da malária na Amazônia brasileira.
Sheila Vitor-Silva (2009). Malaria is associated with poor school performance in an endemic area of the Brazilian Amazon.
Urzula Urbāne (2006). Diagnostic Value of Clinical Presentation, Parental Concern, and Clinician’s Non-Analytical Reasoning in Identifying Serious Bacterial Infections in Febrile Children. Doctoral Thesis.
Wolfarth-Couto,Bruna Filizola,; Naziano,Laurent Durieux (2020). Seasonal pattern of malaria cases and the relationship with hydrological variability in the State of Amazonas, Brazil.
Santos Dos,Pedro Ferreira (2017). The perspectives and divergences about anthropogenic global warming.
Pedro Tauil,Leônidas Deane,Paulo Sabroza,Cláudio Ribeiro (1985). A malária no Brasil.
Antônio Meireles,Fernanda Duarte,Rosilene Cardoso (2020). PANORAMA EPIDEMIOLÓGICO DA MALÁRIA EM UM ESTADO DA AMAZÔNIA BRASILEIRA / EPIDEMIOLOGICAL OVERVIEW OF MALARIA IN A BRAZILIAN AMAZON STATE.
Mathieu Gendrot (2020). Antimalarial artemisinin (ACT) and COVID-19 combination therapies in Africa: In vitro inhibition of Replication of SARS-CoV-2 by mefloquine-artesunate.
Bbc News (2020). Why developing a vaccine is so complex -and not always feasible.
Dorothy Melvin (2020). Manual for the Microscopic Diagnosis of Malaria.
No ethics committee approval was required for this article type.
Data Availability
Not applicable for this article.
How to Cite This Article
Felipe Oliveira Neves. 2026. \u201cOverview of Brazilian Malaria Incidence from Environmental, Economic and Spatial Factors in Amazon and Extra Amazon Region\u201d. Global Journal of Human-Social Science - B: Geography, Environmental Science & Disaster Management GJHSS-B Volume 24 (GJHSS Volume 24 Issue B1).
Explore published articles in an immersive Augmented Reality environment. Our platform converts research papers into interactive 3D books, allowing readers to view and interact with content using AR and VR compatible devices.
Your published article is automatically converted into a realistic 3D book. Flip through pages and read research papers in a more engaging and interactive format.
Subject: Global Journal of Human-Social Science - B: Geography, Environmental Science & Disaster Management
Authors:
Magno De Oliveira, Bruno Henrique Di Napoli Nunes, Agrinazio Geraldo Nascimento Neto, Fernanda Majolo, Guilherme Liberato da Silva, Lucas Vieira (PhD/Dr. count: 0)
Our website is actively being updated, and changes may occur frequently. Please clear your browser cache if needed. For feedback or error reporting, please email [email protected]
Thank you for connecting with us. We will respond to you shortly.